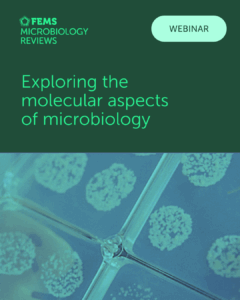

FEMS Microbiology Reviews
Authoritative, high-impact reviews that shape the field of microbiology.
FEMS Microbiology Reviews is a leading microbiology journal dedicated exclusively to authoritative, high-impact review articles. Led and supported by an editorial board of experts, the journal provides comprehensive and critical coverage of the field. Published reviews offer novel, well thought out perspectives, detailed discussions on major developments and emerging trends, and shape discourse advancing understanding within the field. Publishing in FEMS Microbiology Reviews provides authors the opportunity to influence the field and reach a global audience. The reviews we publish are both commissioned by invitation and drawn from high-quality proposals submitted for consideration.
Editors-in-Chief: Prof. Karin Sauer, Binghampton University, New York, USA; and Prof. Bart Thomma, University of Cologne, Institute For Plant Sciences, Germany
Highlights: Comprehensive reviews from invited experts and from carefully selected proposals | Open access

- Why choose FEMS Microbiology Reviews ?
- Submission process
- Recent highlights
- Quick facts
- Meet the Editors-in-Chief
- Publish with purpose. Publish with FEMS
Why choose FEMS Microbiology Reviews?
✅ Publish alongside other thought leaders
With a strong tradition of in-depth, authoritative reviews, the journal prioritizes quality over all else, serving as reference points for researchers, educators, and policymakers.
✅ Open access for maximum visibility and readership
All articles are fully open access, ensuring your work is immediately available to the global microbiology community without subscription barriers.
✅ Collaborative, peer-led editorial process
The review process is grounded in constructive scholarly exchange. Manuscripts are handled by experts in your field, who engage authors as respected colleagues, ensuring the final article reflects intellectual depth and broad relevance across the field.
Submission process:
Although many reviews are commissioned by invitation, we also welcome high-quality proposals from subject matter experts. All proposal submissions are evaluated by the Editors. Authors of approved proposals will be invited to submit a full manuscript through our online system.
We are especially interested in proposals for reviews that provide:
- A comprehensive, critical view of a microbiology topic that has not been surveyed recently and is trending within the field
- New perspectives, future directions, or critical speculation on the existing literature
- Relevance to both specialists and the wider microbiology community
For proposal enquiries, authors are welcome to contact the Editors directly.
Recent highlights
2025 Article Award Winner:
Plant exudates-driven microbiome recruitment and assembly facilitates plant health management
Yang et al. synthesize mechanisms of exudate-mediated microbial recruitment and community assembly.
Thematic issue:
Illuminating Microbial Dark Matter in the Microbiome
Collection delving into various aspects of microbial dark matter and its connection to the microbiome.
Recent webinar:
Exploring the molecular aspects of microbial biology
Recent webinar connected to our thematic issue on the molecular aspects of microbial biology.
Quick Facts
-
Publishing model: Open access
-
Article types: Reviews
-
Review Process: Single anonymised peer review
- Transfer Options: To help authors avoid unnecessary delays and resubmissions, review proposals that demonstrate scientific merit may be offered the option to transfer to another journal within the FEMS portfolio.
Meet the Editors-in-Chief

Prof. Karin Sauer

Prof. Bart Thomma

Prof. Urs Greber
Publish with purpose. Publish with FEMS
The FEMS journal portfolio spans the full spectrum of microbiology, publishing rigorous, society-backed research from fundamental discovery to real-world application.
Stay updated on interesting reads, publishing opportunities, and more by signing up for the FEMS newsletter.